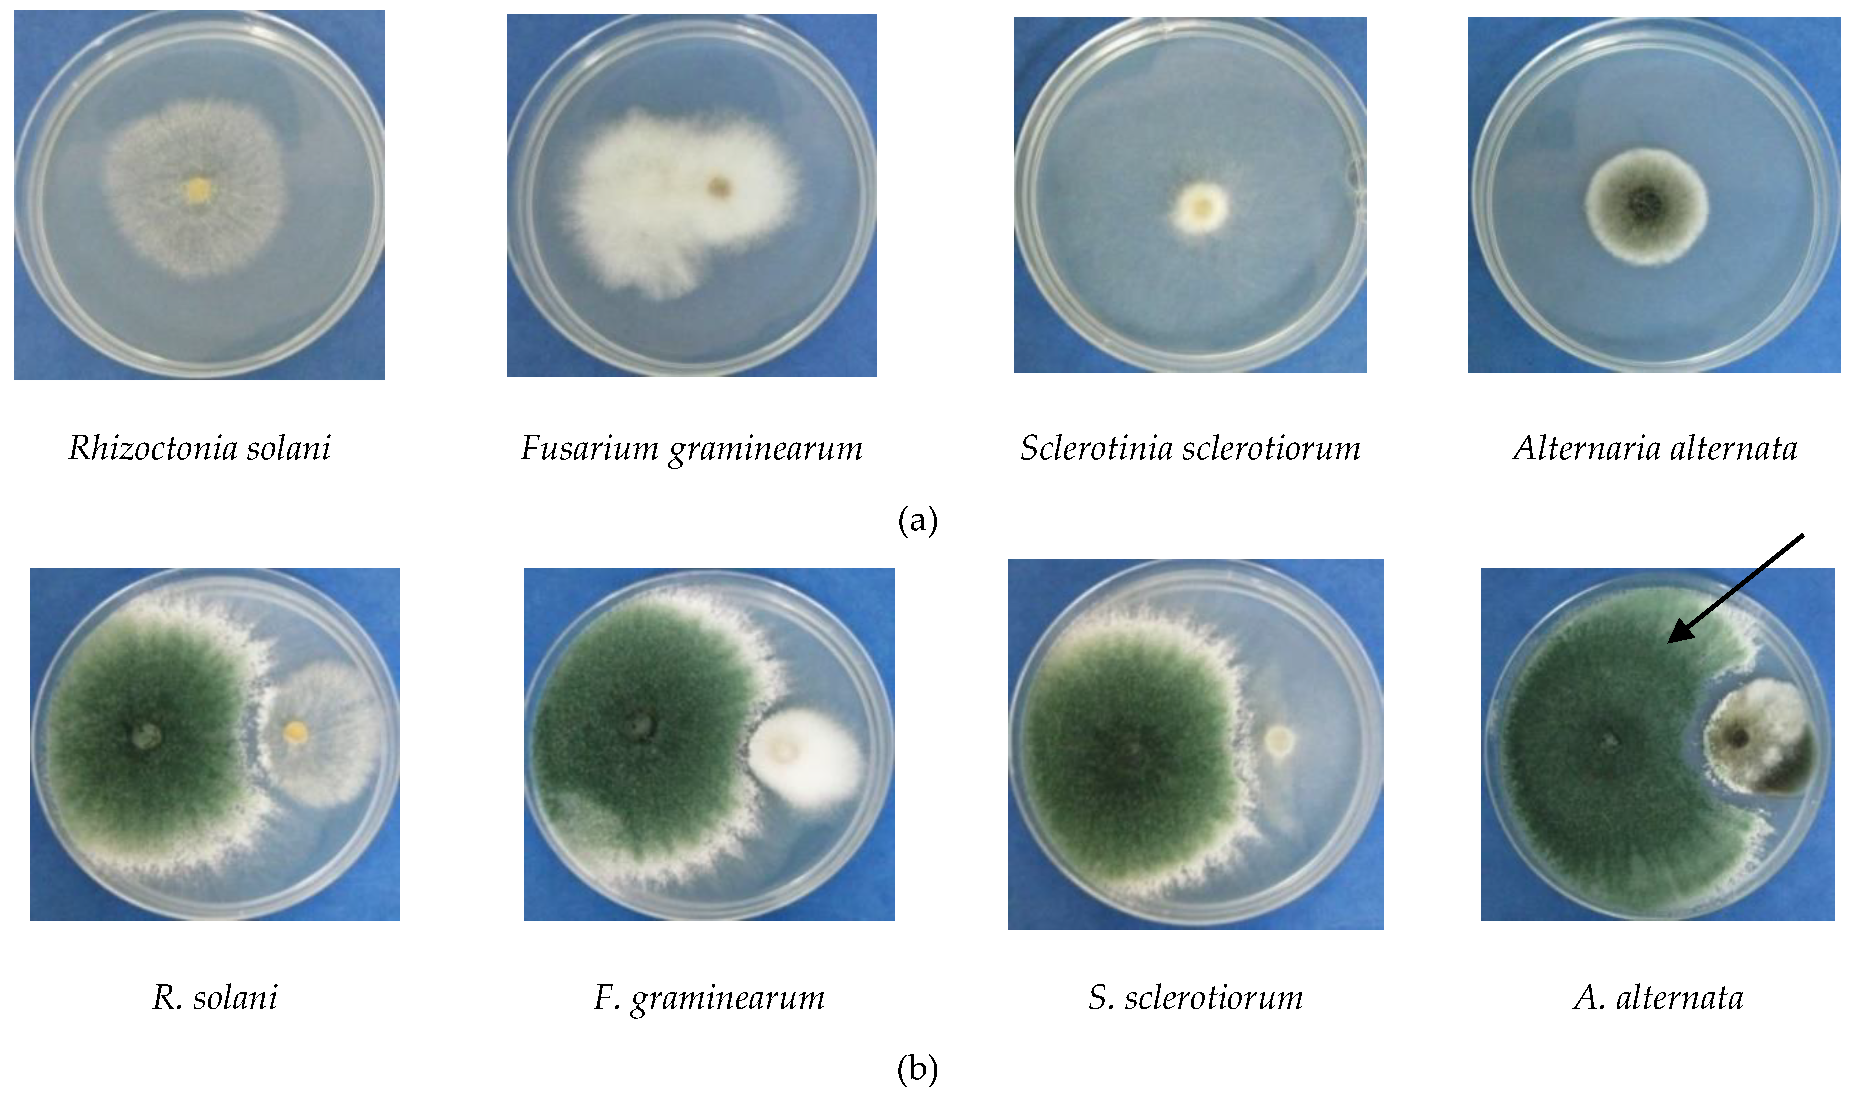
Agronomy 09 00543 g001a
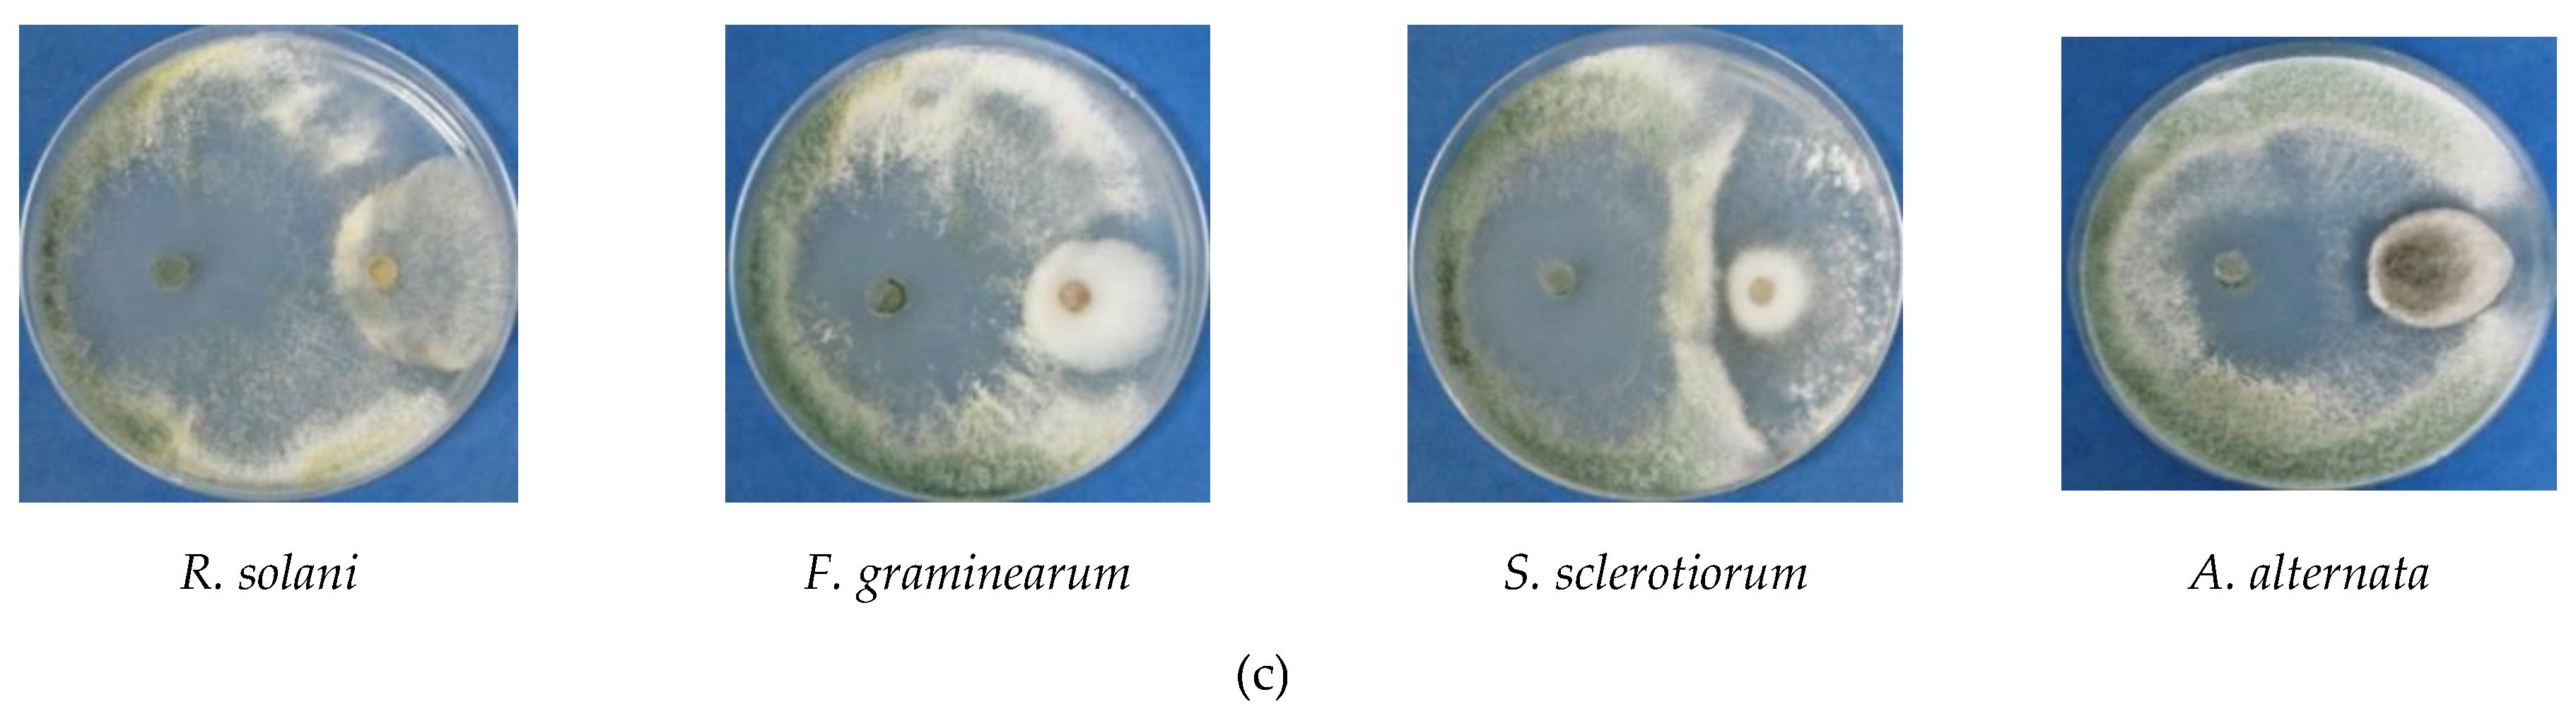
Agronomy 09 00543 g001b
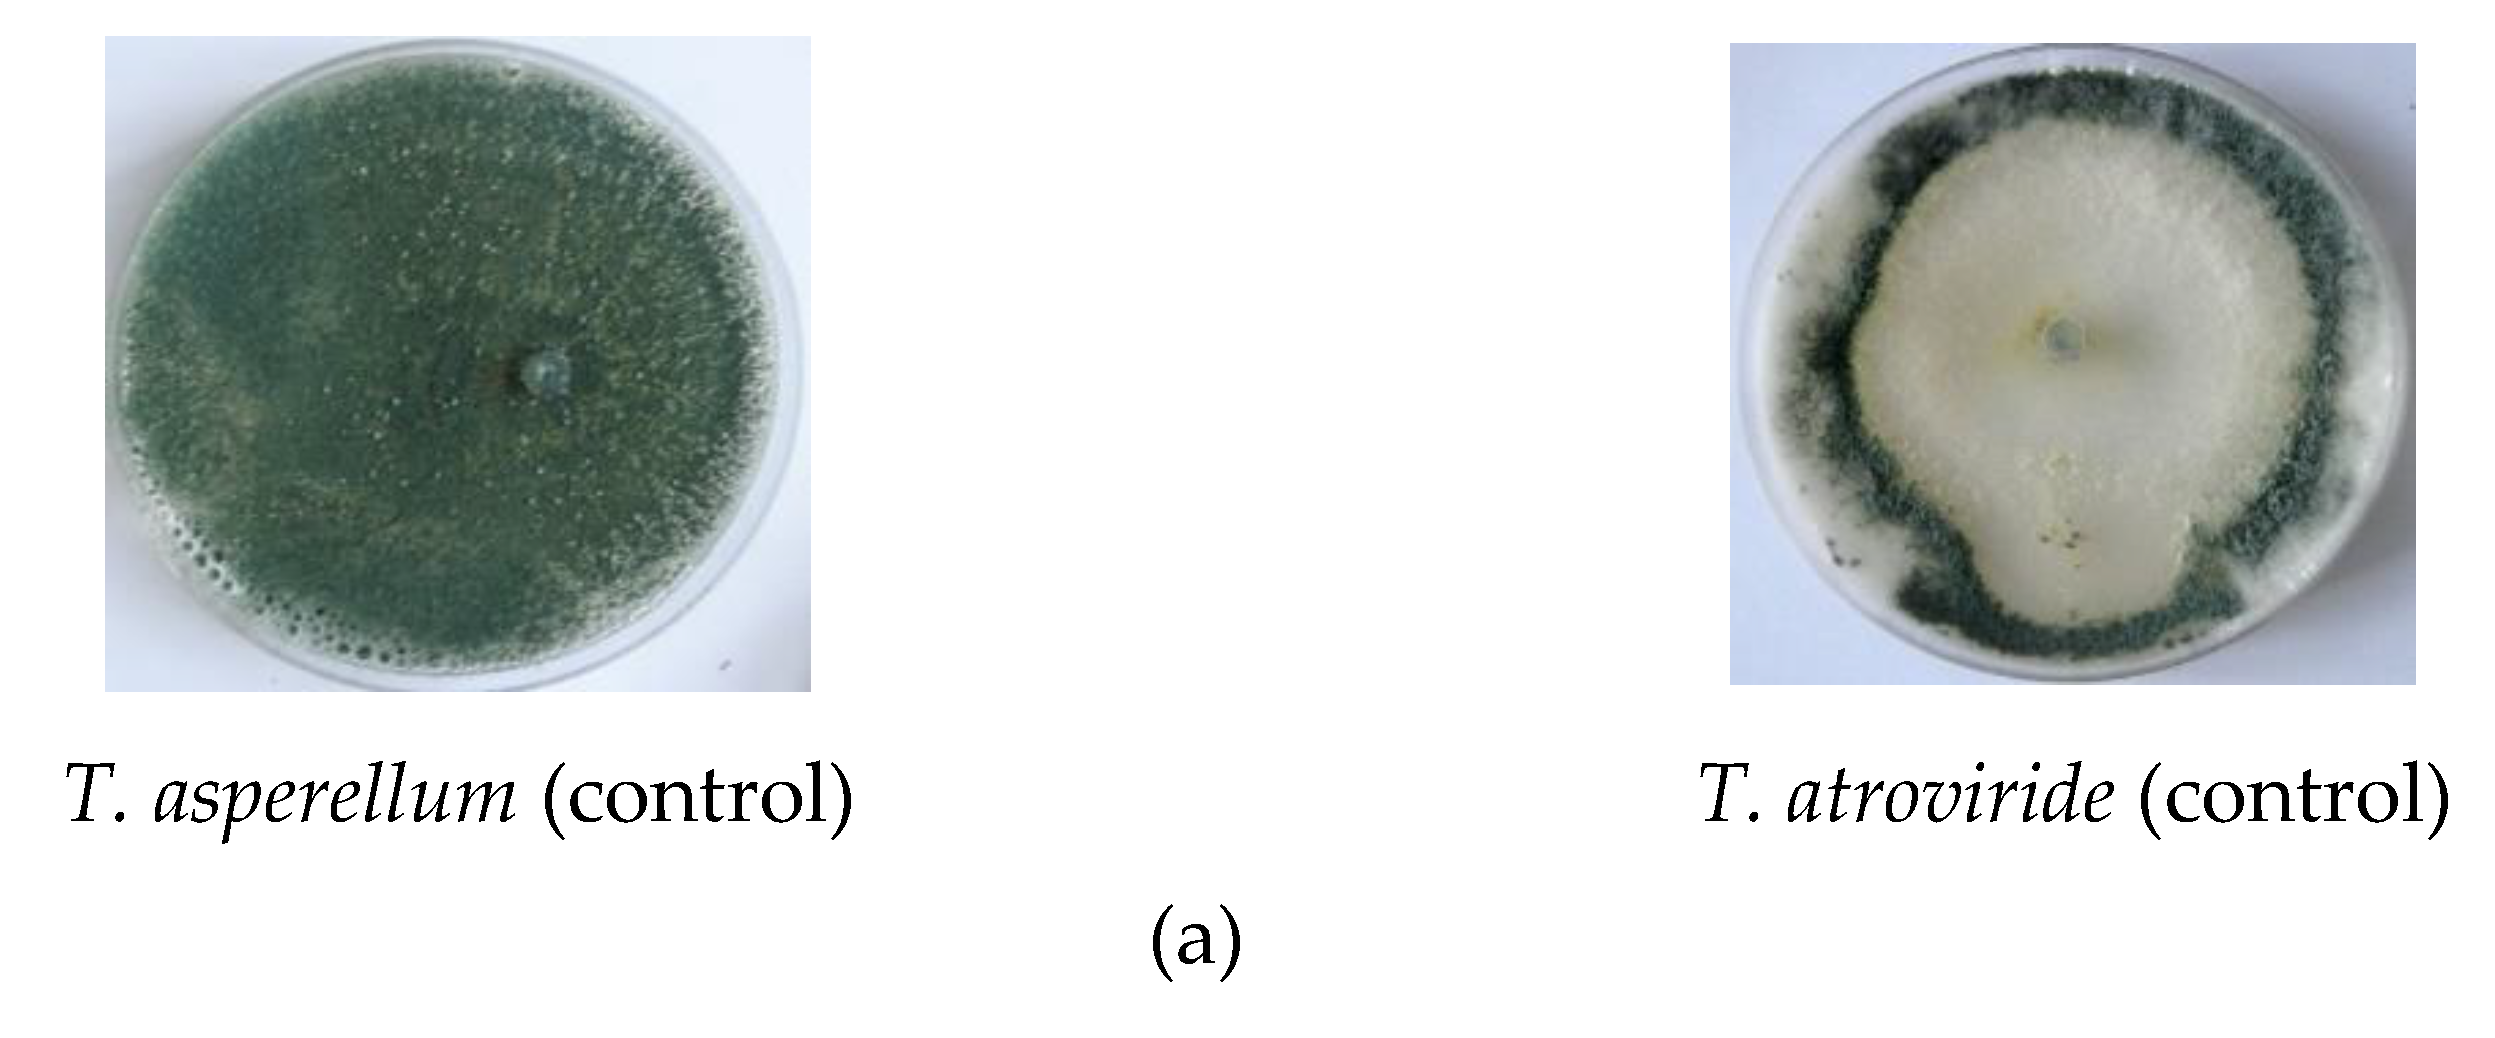
Agronomy 09 00543 g002a
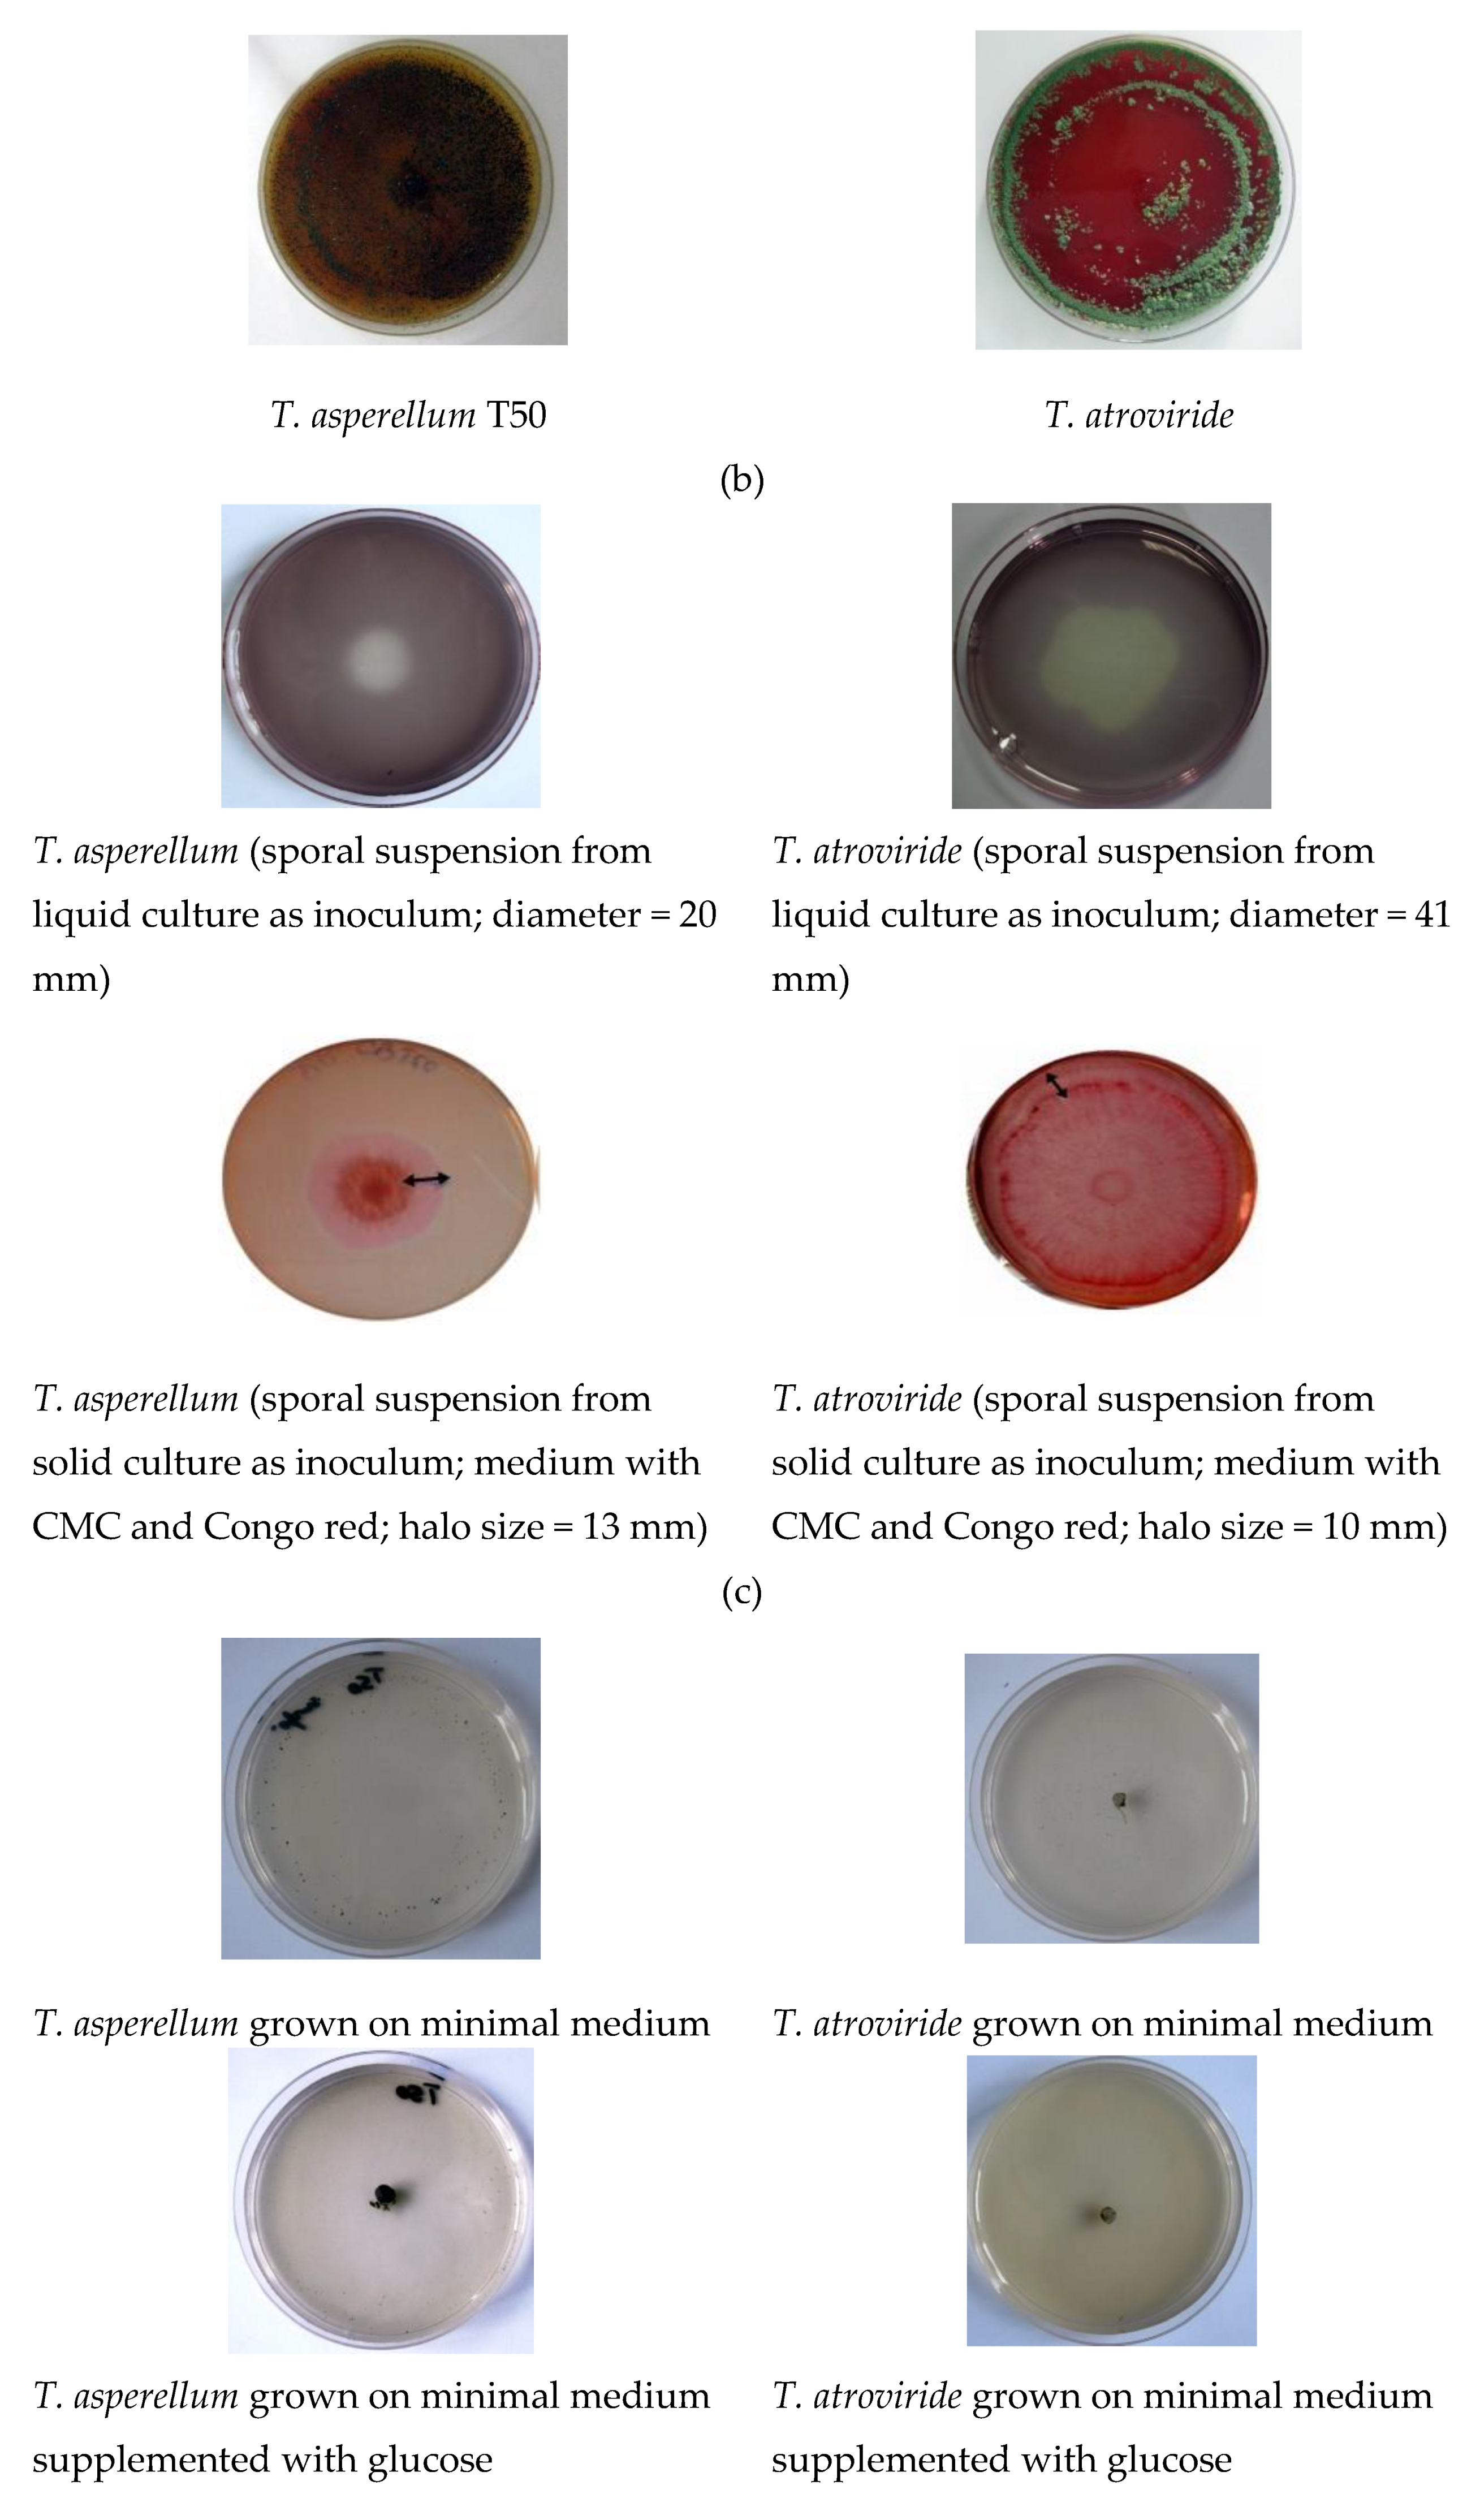
Agronomy 09 00543 g002b
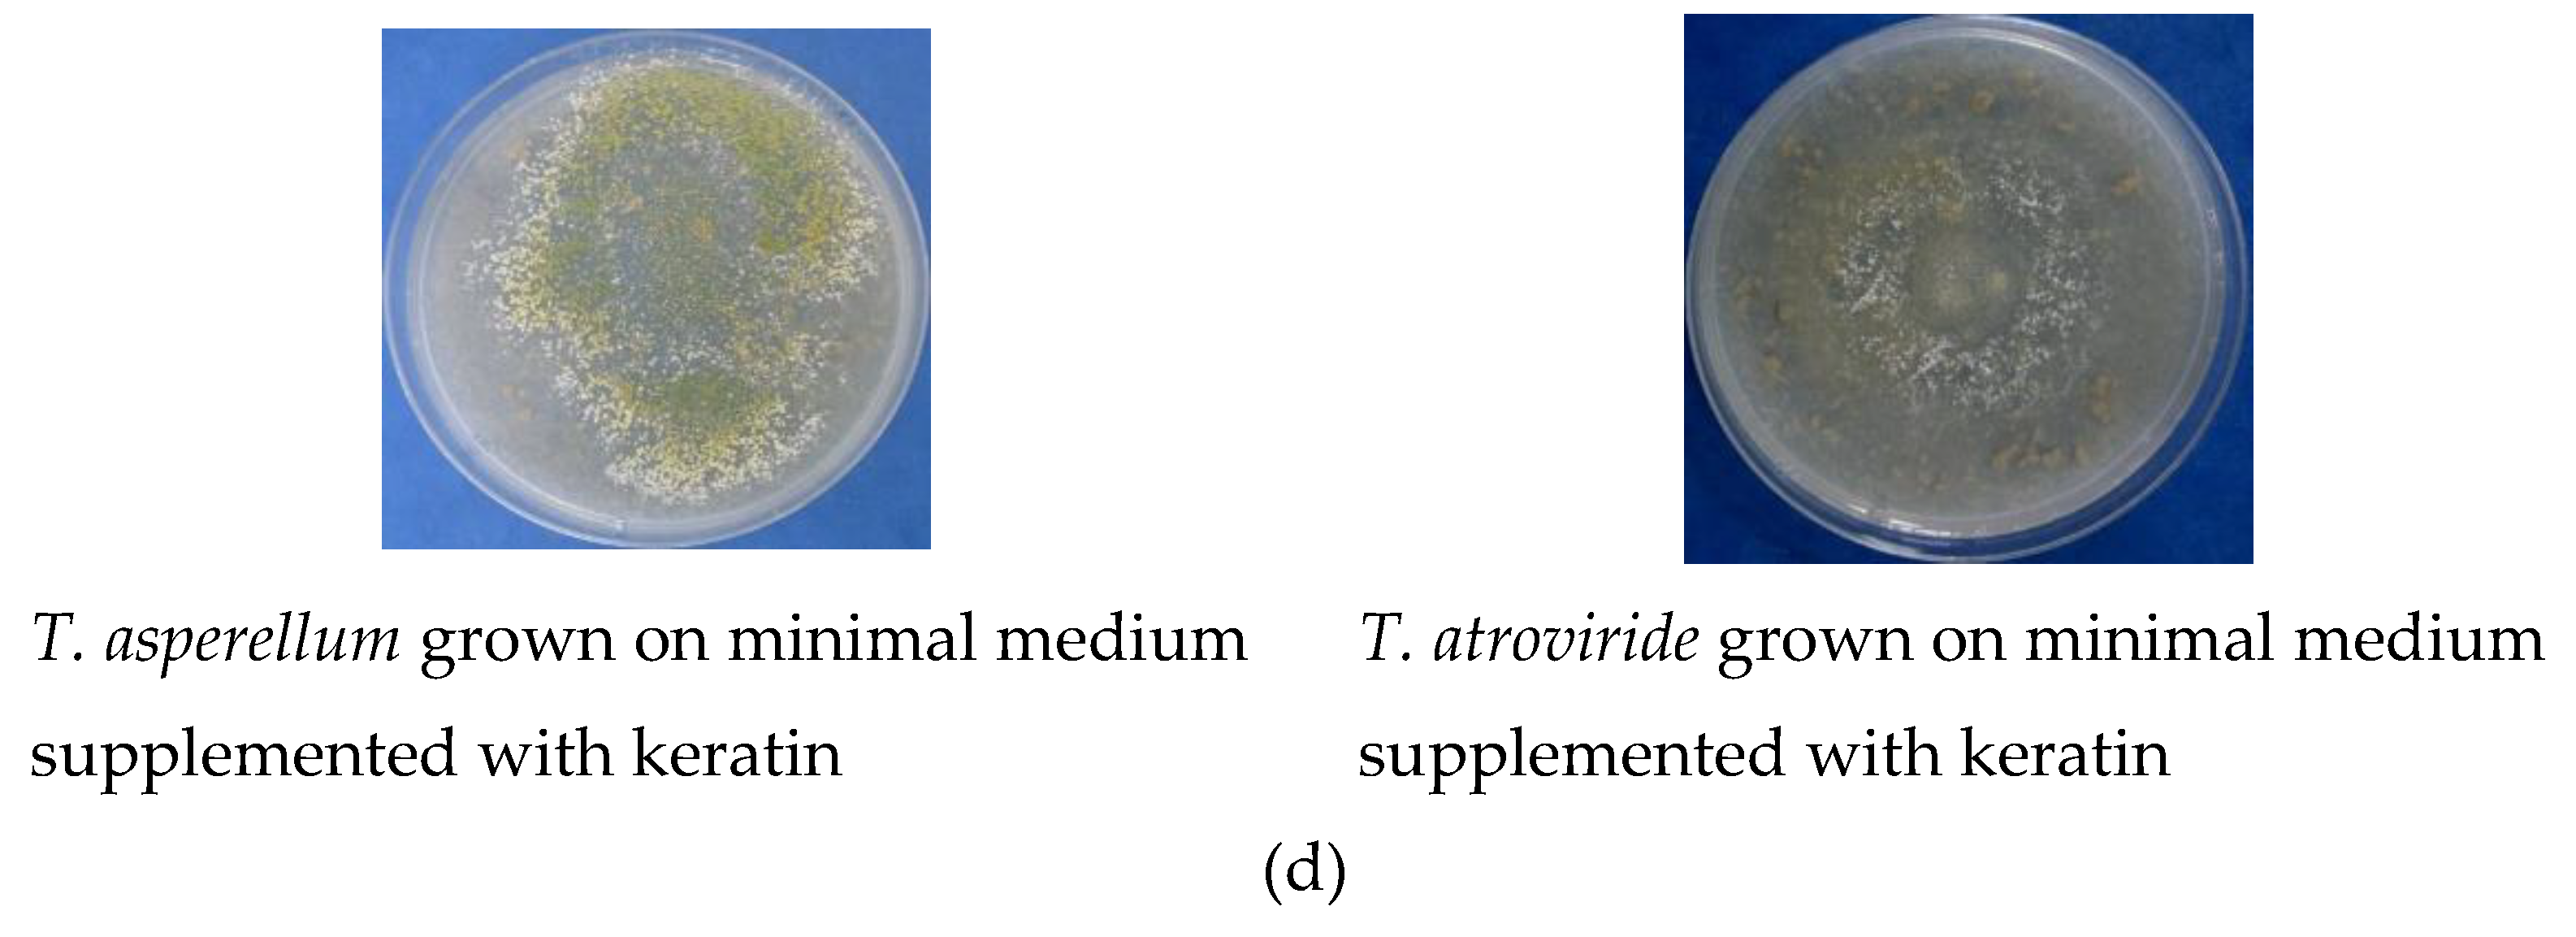
Agronomy 09 00543 g002c
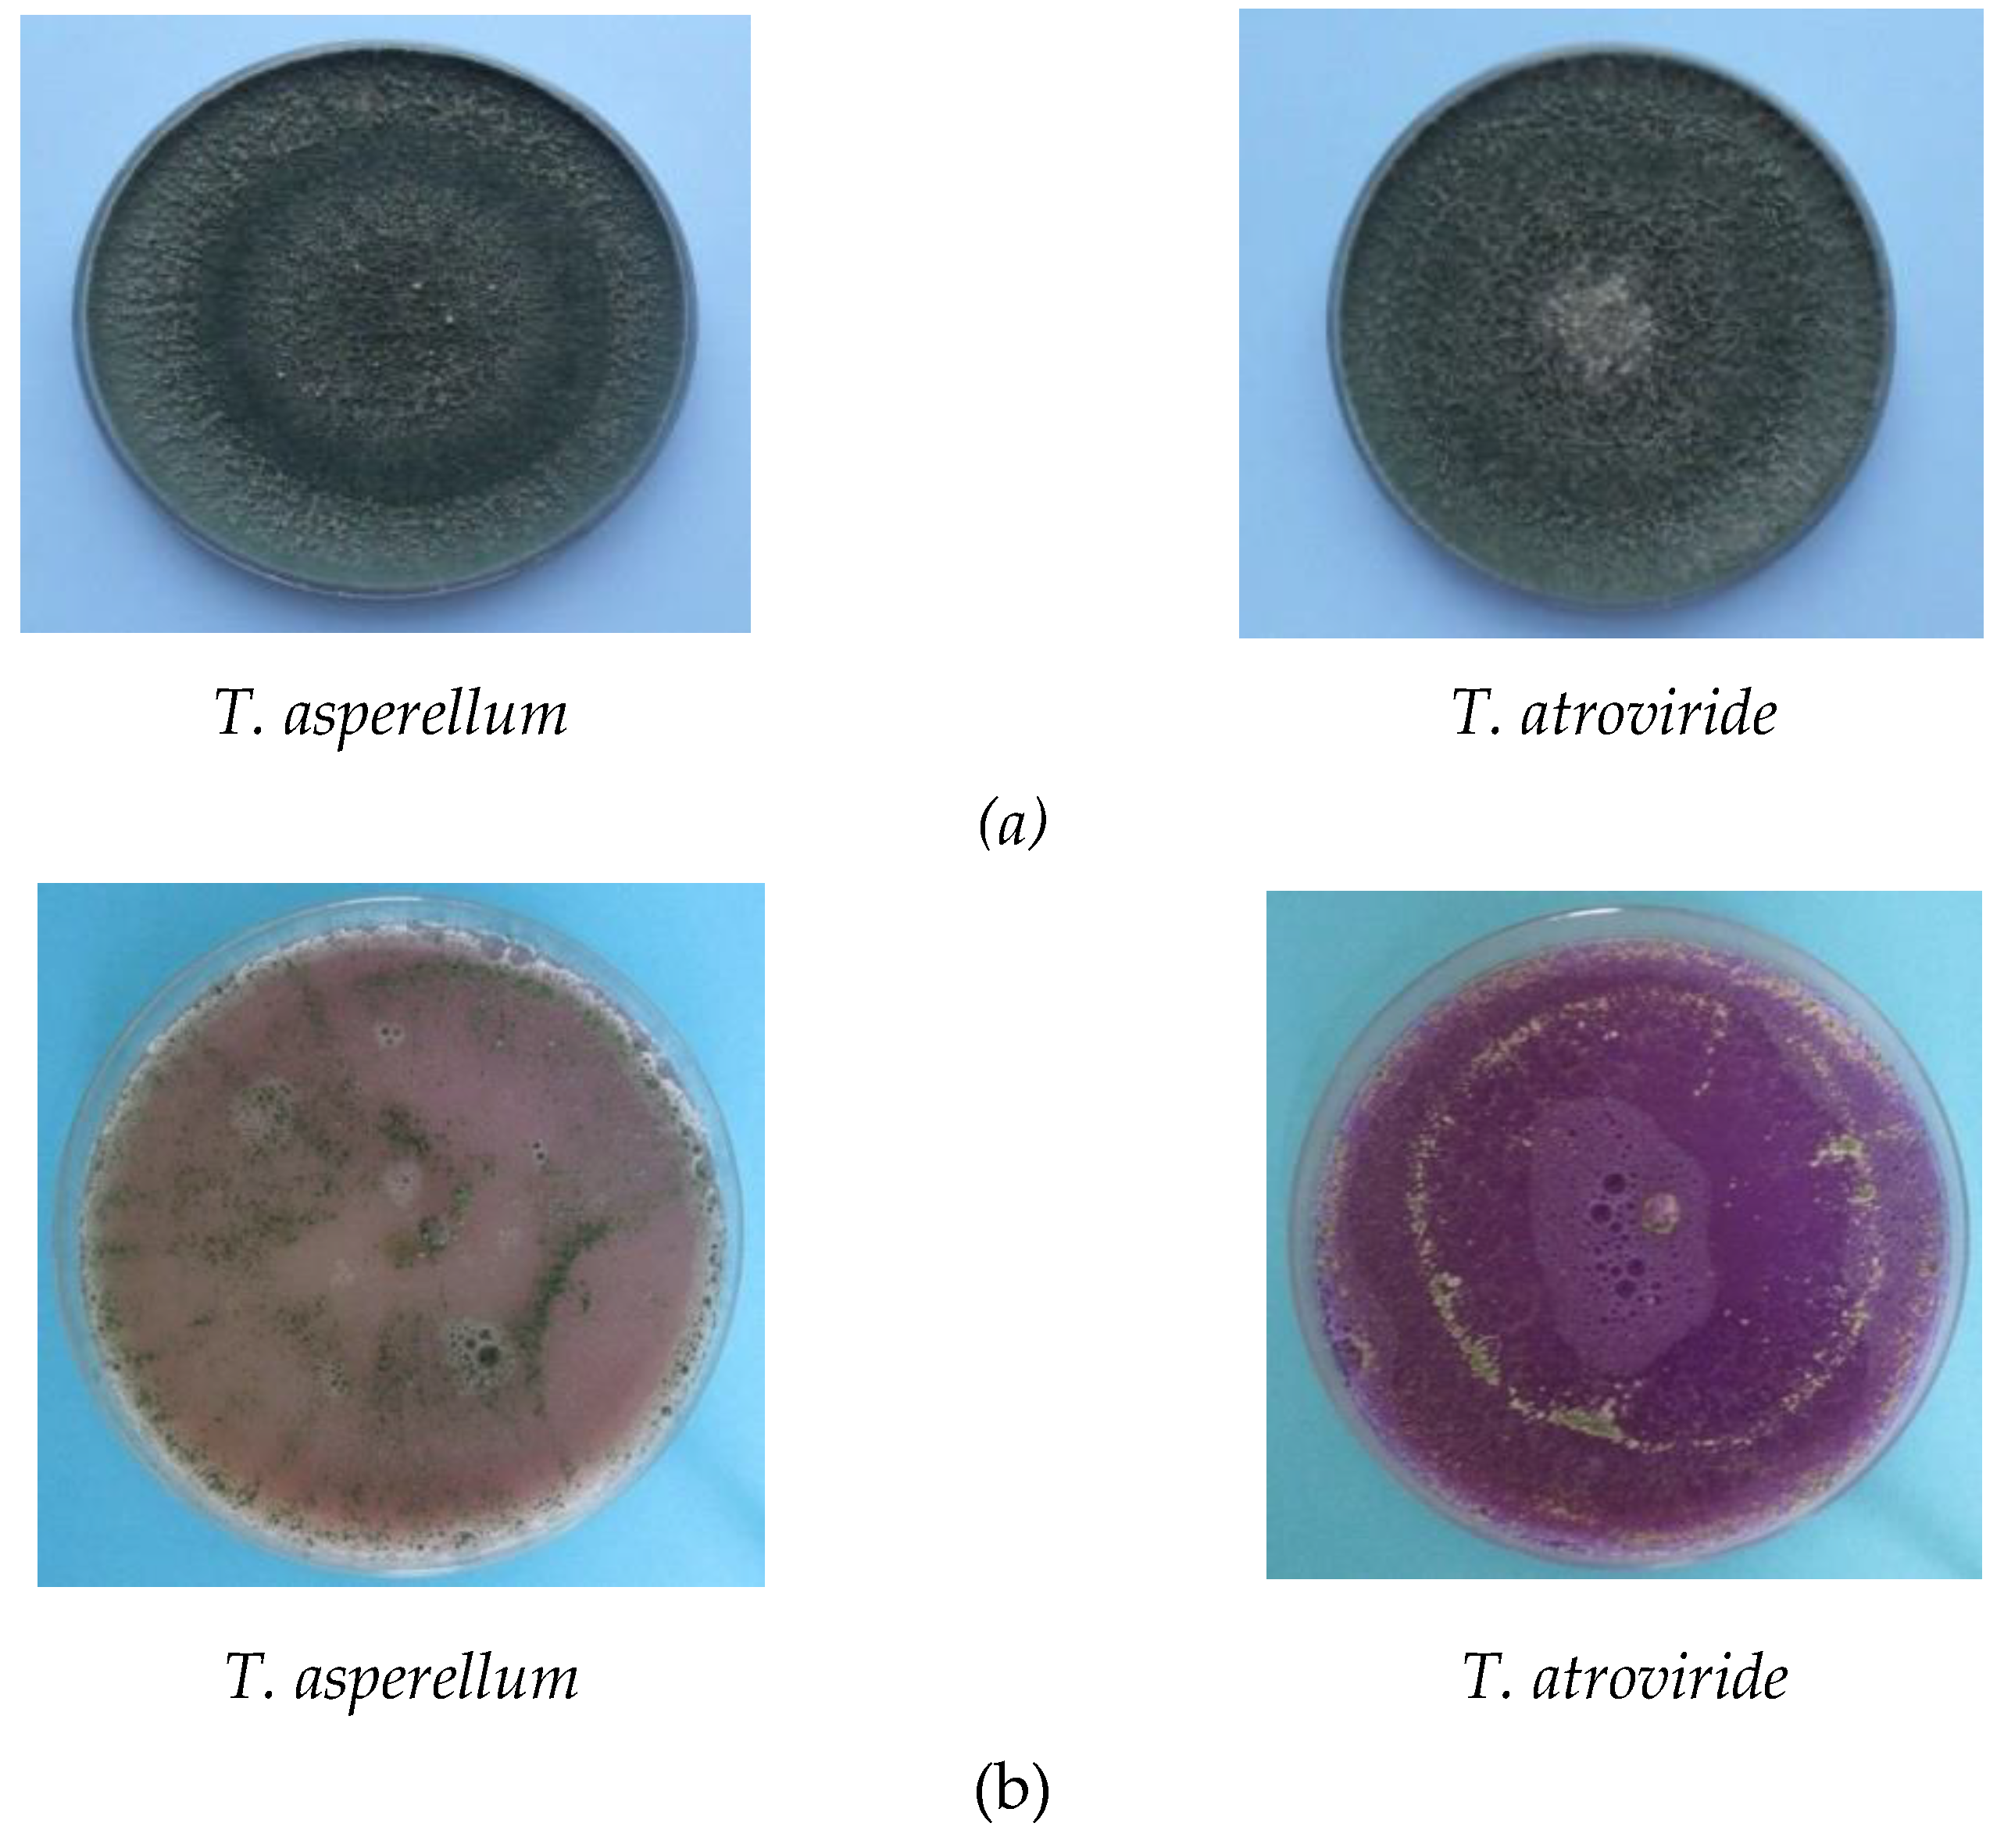
Agronomy 09 00543 g004

Applications of Fungal Strains with Keratin-Degrading and Plant Growth Promoting Characteristics
Abstract
1. Introduction
2. Materials and Methods
2.1. Microorganisms
2.2. In Vitro Promoting Traits of Isolates
2.2.1. Antagonistic Activities Against Pathogenic Fungi
2.2.2. Enzymatic Activities
2.2.3. Production of Indole-3-Acetic Acid (IAA)
2.2.4. Hydroxyquinoline Test for Siderophores Production
2.2.5. Phosphorus Solubilization
2.2.6. Protein Hydrolysates (PHs) Preparation
2.2.7. Nitrogen Content of Protein Hydrolysates
2.3. In Vivo Tests for Biostimulant Activity
2.3.1. Seed Germination
2.3.2. Plant Proton Pump
2.3.3. Test for the Capacity to Promote Plant Growth (Pot Experiment)
3. Results
3.1. Antagonistic Effect
3.2. Enzymatic Activities
3.3. IAA Production
3.4. Phosphate Solubilisation
3.5. Nitrogen Content
3.6. Biostimulating Effect of PHs
3.6.1. Seed Germination
3.6.2. Proton Pump Test
3.6.3. Pot Experiments
4. Discussion
5. Conclusions
Author Contributions
Funding
Acknowledgments
Conflicts of Interest
References
- Howell, C.R. Mechanisms employed by Trichoderma species in the biological control of plant diseases: The history and evolution of current concepts. Plant Dis. 2003, 87, 4–10. [Google Scholar] [CrossRef] [PubMed]
- Harman, G.E. Overview of mechanisms and uses of Trichoderma spp. Phytopathology 2006, 96, 190–194. [Google Scholar] [CrossRef] [PubMed]
- Schuster, A.; Schmoll, M. Biology and biotechnology of Trichoderma. Appl. Microbiol. Biotechnol. 2010, 87, 787–799. [Google Scholar] [CrossRef] [PubMed]
- Heydari, A.; Pessarakli, M. A review on biological control of fungal plant pathogens using microbial antagonists. J. Biol. Sci. 2010, 10, 273–290. [Google Scholar] [CrossRef]
- Błaszczyk, L.; Siwulski, S.; Sobieralski, K.; Lisiecka, J.; Jędryczka, M. Trichoderma spp.—Application and prospects for use in organic farming and industry. J. Plant Prot. Res. 2014, 54, 309–317. [Google Scholar] [CrossRef]
- Naher, L.; Yusuf, U.K.; Ismail, A.; Hossain, K. Trichoderma spp.: A biocontrol agent for sustainable management of plant diseases. Pak. J. Bot. 2014, 46, 1489–1493. [Google Scholar]
- Bashan, Y.; de-Bashan, L.E. How the plant growth-promoting bacterium Azospirillum promotes plant growth—A critical assessment. In Advances in Agronomy; Sparks, D.L., Ed.; Elsevier Academic Press: Amsterdam, The Netherlands, 2010; pp. 77–136. [Google Scholar]
- Saba, H.; Vibhash, D.; Manisha, M.; Prashant, K.; Farhan, H.; Tauseef, A. Trichoderma–A promising plant growth stimulator and biocontrol agent. Mycosphere 2012, 3, 524–531. [Google Scholar] [CrossRef]
- DuJardin, P. Plant biostimulants: Definition, concept, main categories and regulation. Sci. Hort. 2015, 196, 3–14. [Google Scholar] [CrossRef]
- Povero, G.; Mejia, J.F.; Di Tommaso, D.; Piaggesi, A.; Warrior, P. A systematic approach to discover and characterize natural plant biostimulants. Front Plant Sci. 2016, 7. [Google Scholar] [CrossRef]
- Bulgari, R.; Cocetta, G.; Trivellini, A.; Vernieri, P.; Ferrante, A. Biostimulants and crop responses: A review. Biol. Agric. Hortic. 2015, 31, 1–17. [Google Scholar] [CrossRef]
- Bulgari, R.; Morgutti, S.; Cocetta, G.; Negrini, N.; Farris, S.; Calcante, A.; Spinardi, A.; Ferrari, E.; Mignani, I.; Oberti, R.; et al. Evaluation of borage extracts as potential biostimulant using a phenomic, agronomic, physiological, and biochemical approach. Front Plant Sci. 2017, 8. [Google Scholar] [CrossRef] [PubMed]
- Yakhin, O.I.; Lubyanov, A.A.; Yakhin, I.A.; Brown, P.H. Biostimulants in plant science: A global perspective. Front Plant Sci. 2017, 7, 2049. [Google Scholar] [CrossRef] [PubMed]
- Rouphael, Y.; Colla, G. Synergistic biostimulatory action: Designing the next generation of plant biostimulants for sustainable agriculture. Front Plant Sci. 2018, 9. [Google Scholar] [CrossRef] [PubMed]
- European Commission. Proposal for a Regulation Laying Down Rules on the Making Available on the Market of CE Marked Fertilizing Products and Amending Regulations (EC)1069/2009 and (EC)1107/2009.COM; Brussels European Commission: Brussels, Belgium, 2016; p. 157. [Google Scholar]
- Colla, G.; Nardi, S.; Cardarelli, M.; Ertani, A.; Lucini, L.; Canaguier, R.; Rouphael, Y. Protein hydrolysates as biostimulants in horticulture. Sci. Hort. 2015, 196, 28–38. [Google Scholar] [CrossRef]
- Kornillowicz-Kowalska, T.; Bohacz, J. Biodegradation of keratin waste: Theory and practical aspects. Waste Manag. 2011, 3, 1689–1701. [Google Scholar] [CrossRef] [PubMed]
- Sinkiewicz, I.; Sliwinska, A.; Staroszczyk, H.; Kołodziejska, I. Alternative methods of preparation of soluble keratin from chicken feathers. Waste Biomass Valor. 2017, 8, 1043–1048. [Google Scholar] [CrossRef]
- Begum, M.F.; Rahman, M.A.; Alam, F.M. Biological control of alternaria fruit rot of chili by Trichoderma species under field conditions. Mycobiology 2010, 38, 113–117. [Google Scholar] [CrossRef] [PubMed]
- Agrawal, T.; Kotasthane, A.S. Chitinolytic assay of indigenous Trichoderma isolates collected from different geographical locations of Chhattisgarh in Central India. SpringerPlus 2012, 1, 73. [Google Scholar] [CrossRef] [PubMed]
- Yoon, J.H.; Park, J.E.; Dong, Y.S.; Hong, S.B.; Ko, S.J.; Kim, S.H. Comparison of dyes for easy detection of extracellular cellulases in fungi. Mycobiology 2007, 35, 21–24. [Google Scholar] [CrossRef] [PubMed][Green Version]
- Lateef, A.; Adelere, A.I.; Gueguim-Kana, E.B. Bacillus safensis LAU 13: A new source of keratinase and its multi-functional biocatalytic applications. Biotechnol. Biotechnol. Equip. 2015, 29, 54–63. [Google Scholar] [CrossRef] [PubMed]
- Bhange, K.; Chaturvedi, V.; Bhatt, R. Ameliorating effects of chicken feathers in plant growth promotion activity by a keratinolytic strain of Bacillus subtilis PF1. Bioresour Bioprocess 2016, 3, 13. [Google Scholar] [CrossRef]
- Gordon, S.A.; Weber, R.P. Colorimetric estimation of indole acetic acid. Plant Physiol. 1951, 26, 192–195. [Google Scholar] [CrossRef] [PubMed]
- Gutierrez, C.K.; Matsuy, G.Y.; Lincoln, D.E.; Lovel, C.R. Production of the phytohormone indole-3 acetic acid by the estuarine spesies of the genus Vibrio. Appl Environ Microbiol. 2009, 75, 2253–2258. [Google Scholar] [CrossRef] [PubMed]
- De Brito, A.M.; Gagne, S.; Antoun, H. Effect of compost on rhizosphere microflora of the tomato and on the incidence of plant growth-promoting rhizobacteria. Appl Environ Microbiol. 1995, 61, 194–199. [Google Scholar] [PubMed]
- Carvajal, L.H.; Bissett, J.; Orduz, S. Growth stimulation in bean (Phaseolus vulgaris L.) by Trichoderma. Biol Control 2009, 51, 409–416. [Google Scholar] [CrossRef]
- Vazquez, P.; Holgui, G.; Puente, M.E.; Lopez-Cortes, A.; Bashan, Y. Phosphate-solubilizing microorganisms associated with the rhizosphere of mangroves in a semiarid coastal lagoon. Biol. Fertil. Soils 2000, 30, 460–468. [Google Scholar] [CrossRef]
- Paul, T.; Halder, S.K.; Das, A.; Bera, S.; Maity, C.; Mandal, A.; Das, P.S.; Pradeep, K.; Das, M.; Pati, B.R.; et al. Exploitation of chicken feather waste as a plant growth promoting agent using keratinase producing novel isolate Paenibacillus woosongensis TKB2. Biocatal. Agric. Biotechnol. 2013, 2, 50–57. [Google Scholar] [CrossRef]
- Popko, M.; Wilk, R.; Górecka, H.; Chojnacka, K.; Henryk Górecki, H. Assessment of new NKSMg fertilizer based on protein hydrolysate of keratin in pot experiments. Pol. J. Environ. Stud. 2015, 24, 1765–1772. [Google Scholar] [CrossRef]
- Sáez-Plaza, P.; Michałowski, T.; Navas, M.J.; Asuero, A.G.; Wybraniec, S. An overview of the Kjeldahl method of nitrogen determination. Part I. Early history, chemistry of the procedure, and titrimetric finish. Crit. Rev. Anal. Chem. 2013, 43, 178–223. [Google Scholar] [CrossRef]
- Zandonadi, D.B.; Santos, M.P.; Caixeta, L.S.; Marinho, E.B.; Pereira Peres, L.E.; Façanha, A.R. Plant proton pumps as markers of biostimulant action. Sci. Agri. 2016, 73, 24–28. [Google Scholar] [CrossRef]
- Cavello, I.A.; Crespo, J.M.; García, S.S.; Zapiola, J.M.; Luna, M.F.; Cavalitto, S.F. Plant growth promotion activity of keratinolytic fungi growing on a recalcitrant waste known as (hair waste). Biotechnol. Res. Int. 2015. [Google Scholar] [CrossRef] [PubMed]
- Rajkumar, M.; Freitas, H. Effects of inoculation of plantgrowth promoting bacteria on Ni uptake by Indian mustard. Biores. Technol. 2008, 99, 3491–3498. [Google Scholar] [CrossRef] [PubMed]
- Gajera, H.; Domadiya, R.; Patel, S.; Kapopara, M.; Golakiya, B. Molecular mechanism of Trichoderma as bio-control agents against phytopathogen system–A review. Curr. Res. Microbiol. Biotechnol. 2013, 1, 133–142. [Google Scholar]
- Gousterova, A.; Nustorova, M.; Paskaleva, D.; Naydenov, M.; Neshev, G.; Tonkova, V.E. Assessment of feather hydrolysate from thermophilic actinomycetes for soil amendment and biological control application. Int. J. Environ. Res. 2012, 6, 467–474. [Google Scholar]
- Kumar, M.; Ashraf, S. Role of Trichoderma spp. as a biocontrol agent of fungal plant pathogens. In Probiotics and Plant Health; Kumar, V., Kumar, M., Sharma, S., Prasad, R., Eds.; Springer Nature Singapore Private Limited: Singapore, 2017; pp. 497–506. [Google Scholar]
- Abbasi, S.; Safaie, N.; Shams-Bakhsh, M.; Shahbazi, S. Biocontrol activities of gamma induced mutants of Trichoderma harzianum against some soilborne fungal pathogens and their DNA fingerprinting. Iran J. Biotechnol. 2016, 14, 260–269. [Google Scholar] [CrossRef] [PubMed]
- Mishra, B.K.; Mishra, R.K.; Mishra, R.C.; Tiwari, A.K.; Singh, Y.R.; Dikshit, A. Biocontrol efficacy of Trichoderma viride isolates against fungal plant pathogens causing disease in Vigna radiata L. Arch. Appl. Sci. Res. 2011, 3, 361–369. [Google Scholar]
- Redda, E.T.; Ma, J.; Mei, J.; Li, M.; Wu, B.; Jiang, X. Antagonistic potential of different isolates of Trichoderma against Fusarium oxysporum, Rhizoctonia solani and Botrytis cinereal. Eur. J. Exp. Biol. 2018, 8, 1–12. [Google Scholar] [CrossRef]
- Wu, Q.; Sun, R.; Ni, M.; Yu, J.; Li, Y.; Yu, C.; Dou, K.; Ren, J.; Chen, J. Identification of a novel fungus, Trichoderma asperellum GDFS1009, and comprehensive evaluation of its biocontrol efficacy. PLoS ONE 2017, 12, e0179957. [Google Scholar] [CrossRef] [PubMed]
- Ting, A.S.Y.; Chai, J.Y. Chitinase and β-1,3-glucanase activities of Trichoderma harzianum in response towards pathogenic and non-pathogenic isolates: Early indications of compatibility in consortium. Biocatal. Agric. Biotechnol. 2015, 4, 109–113. [Google Scholar] [CrossRef]
- Khatri, D.K.; Tiwari, D.N.; Bariya, H.S. Chitinolytic efficacy and secretion of cell wall-degrading enzymes from Trichoderma spp. in response to phytopathological fungi. J. App. Biol. Biotech. 2017, 5, 1–8. [Google Scholar] [CrossRef]
- Friedrich, J.; Gradis, H.; Mandin, D.; Chaumont, J.P. Screening fungi for synthesis of keratinolytic enzymes. Lett. Appl. Microbiol. 1999, 28, 127–130. [Google Scholar] [CrossRef]
- Bashan, Y.; Singh, M.; Levanony, H. Contribution of Azospirillum brasilense Cd to growth of tomato seedlings is not through nitrogen fixation. Can. J. Bot. 1989, 67, 2429–2434. [Google Scholar] [CrossRef]
- Beyeler, M.; Keel, C.; Michaux, P.; Haas, D. Enhanced production of indole-3-acetic acid by a genetically modified strain of Pseudomonas fluorescens CHA0 affects root growth of cucumber, but does not improve protection of the plant against Pythium root rot. FEMS Microbiol. Ecol. 1999, 28, 225–233. [Google Scholar] [CrossRef][Green Version]
- Upadhyay, A.; Srivastava, S. Evaluation of multiple plant growth promoting traits of an isolate of Pseudomonas fluorescens strain Psd. Ind. J. Exp. Biol. 2010, 48, 601–609. [Google Scholar] [CrossRef]
- Fu, S.F.; Wei, J.Y.; Chen, H.W.; Liu, Y.T.; Lu, H.Y.; Chou, J.Y. Indole-3-acetic acid: A widespread physiological code in interactions of fungi with other organisms. Plant Signal Behav. 2015, 10, e1048052. [Google Scholar] [CrossRef] [PubMed]
- Fu, J.; Wang, S. Insights into auxin signaling in plant-pathogen interactions. Front Plant Sci. 2011, 2. [Google Scholar] [CrossRef]
- Wesam, I.A.S.; Ghoneem, K.M.; Rashad, Y.M.; Al-Askar, A.A. Trichoderma Harzianum WKY1: An indole acetic acid producer for growth improvement and anthracnose disease control in sorghum. Biocontrol Sci. Technol. 2017, 27, 654–676. [Google Scholar] [CrossRef]
- Numponsak, T.; Kumla, J.; Suwannarach, N.; Matsui, K.; Lumyong, S. Biosynthetic pathway and optimal conditions for the production of indole-3-acetic acid by an endophytic fungus, Colletotrichum fructicola CMU-A109. PLoS ONE 2018, 13, e0205070. [Google Scholar] [CrossRef] [PubMed]
- Abri, T.K.; Sengin, E.L.; Sjahrir, R. Production of Indole Acetic Acid (IAA) hormone from fungal isolates collected from rhizosphere of aromatic rice in Tana Toraja. Int. J. Curr. Res. Biosc. Plant Biol. 2015, 2, 198–201. [Google Scholar]
- Srivastava, M.P.; Tiwari, R.; Sharma, N. Effect of different cultural variables on siderophores produced by Trichoderma spp. Int. J. Adv. Res. 2013, 1, 1–6. [Google Scholar]
- Banerjee, A.; Bareh, D.A.; Joshi, S.R. Native microorganisms as potent bioinoculants for plant growth promotion in shifting agriculture (Jhum) systems. J. Soil Sci. Plant Nutr. 2017, 17, 127–140. [Google Scholar] [CrossRef]
- Srinivasan, R.; Yandigeri, M.S.; Kashyap, S.; Alagawadi, A.R. Effect of salt on survival and P-solubilization potential of phosphate solubilizing microorganisms from salt affected soils. Saudi J. Biol Sci. 2012, 19, 427–434. [Google Scholar] [CrossRef] [PubMed]
- Sharma, S.B.; Sayyed, R.Z.; Trivedi, M.H.; Gobi, T.A. Phosphate solubilizing microbes: Sustainable approach for managing phosphorus deficiency in agricultural soils. SpringerPlus 2013, 2, 587–600. [Google Scholar] [CrossRef] [PubMed]
- Alori, E.T.; Glick, B.R.; Babalola, O.O. Microbial phosphorus solubilization and its potential for use in sustainable agriculture. Front Microbiol. 2017, 8. [Google Scholar] [CrossRef] [PubMed]
- Bargaz, A.; Lyamlouli, K.; Chtouki, M.; Zeroual, Y.; Dhiba, D. Soil Microbial resources for improving fertilizers efficiency in an integrated plant nutrient management system. Front Microbiol. 2018, 9. [Google Scholar] [CrossRef] [PubMed]
- Wang, H.; Liu, S.; Zhal, L.; Zhang, J.; Ren, T.; Fan, B.Q.; Liu, H.B. Preparation and utilization of phosphate biofertilizers using agricultural waste. J. Integr. Agric. 2015, 14, 158–167. [Google Scholar] [CrossRef]
- Jain, R.; Sharma, V.; Saxena, J. Solubilization of inorganic phosphates by Aspergillus awamori S19 isolated from rhizosphere soil of a semi-arid region. Ann. Microbiol. 2011, 62, 725–735. [Google Scholar] [CrossRef]
- Gaxiola, R.A.; Palmgren, M.G.; Schumacher, K. Plant proton pumps. FEBS Lett. 2007, 581, 2204–2214. [Google Scholar] [CrossRef] [PubMed]
- Ertani, A.; Cavani, L.; Pizzeghello, D.; Brandellero, E.; Altissimo, A.; Ciavatta, C.; Nardi, S. Biostimulant activities of two protein hydrolysates on the growth and nitrogen metabolism in maize seedlings. J. Plant Nutr. Soil Sci. 2009, 172, 237–244. [Google Scholar] [CrossRef]
- Sestili, F.; Rouphael, Y.; Cardarelli, M.; Pucci, A.; Bonini, P.; Canaguier, R.; Colla, G. Protein hydrolysate stimulates growth in tomato coupled with N-dependent gene expression involved in N assimilation. Front Plant Sci. 2018, 9. [Google Scholar] [CrossRef]
- Kim, J.M.; Choi, Y.M.; Suh, H.J. Preparation of feather digests as fertilizer with Bacillus pumilis KHS-1. J. Microbiol. Biotechnol. 2005, 15, 472–476. [Google Scholar]
- Verma, J.P.; Yadav, J.; Tiwari, K.N.; Jaiswal, D.K. Evaluation of plant growth promoting activities of microbial strainsand their effect on growth and yield of chickpea (Cicer arietinum L.) in India. Soil Biol. Biochem. 2014, 70, 33–37. [Google Scholar] [CrossRef]

| Antagonist | Pathogen | Colony Diameter of Pathogen (cm) | Inhibition (%) | |
|---|---|---|---|---|
| In Presence of Antagonist | Control | |||
| T. asperellum | R. solani | 3.35 ± 0.02 | 5.00 ± 0.15 | 32.92 |
| S. sclerotiorum. | 3.05 ± 0.11 | 7.50 ± 0.21 | 59.32 | |
| F. graminearum | 3.00 ± 0.12 | 6.40 ± 0.19 | 53.13 | |
| A. alternata | 2.80 ± 0.07 | 4.40 ± 0.21 | 36.42 | |
| T. atroviridae | R. solani | 3.10 ± 0.08 | 5.00 ± 0.14 | 38.02 |
| S. sclerotiorum. | 3.35 ± 0.06 | 7.50 ± 0.35 | 55.33 | |
| F. graminearum | 2.50 ± 0.05 | 6.40 ± 0.18 | 60.93 | |
| A. alternata | 2.80 ± 0.08 | 4.40 ± 0.28 | 36.47a | |
| Strain | DO530 nm (PDA Medium) | DO530 nm (PDA with L-Tryptophan) |
|---|---|---|
| T. asperellum T50 | 0.044 ± 0.002 | 0.075 ± 0.003 |
| T. atroviride | 0.045 ± 0.001 | 0.050 ± 0.001 |
| Control (culture medium) | 0.041 ± 0.002 | 0.042 ± 0.001 |
| Strain | Keratinic Substrate | Nitrogen Content (mg % g) | ||||
|---|---|---|---|---|---|---|
| Ammonia Nitrogen | Protein Nitrogen | Nitric Nitrogen | Total Protein * | Total Nitrogen | ||
| Trichoderma atroviridae | Feathers | 15.5 | 1.4 | 1.6 | 8.75 | 18.5 |
| Trichoderma atroviridae | Wool | 16.5 | <0.3 ** | <0.3 ** | - | 16.5 |
| Trichoderma asperellum | Feathers | 15.0 | 3.0 | Not detected | 18.8 | 18.0 |
| Trichoderma asperellum | Wool | 9.5 | 2.3 | 0.6 | 14.4 | 12.4 |
| Strain | 10 min Exposure | 60 min Exposure | ||||
|---|---|---|---|---|---|---|
| Control (Medium without Keratin) | Feathers | Wool | Control (Medium without Keratin) | Feathers | Wool | |
| T. atroviride | - | + | ++ | - | - | ++ |
| T. asperellum | - | +++ | +++ | - | +++ | + |
| HPs from Trichoderma Isolates | Total Biomass (g) | Plant Height (cm) | Stem Diameter (mm) | Branches Number /Plant | Leaves Number/Plant |
|---|---|---|---|---|---|
| T. atroviridae on medium without keratin | 1.31 ± 0.01 | 25.33 ± 0.08 | 2.55 ± 0.08 | 7.33 ± 0.02 | 33.00 ± 1.00 |
| T. atroviridae grown on feathers medium | 0.88 ± 0.01 | 17.33 ± 0.23 | 2.60 ± 0.06 | 5.66 ± 0.06 | 25.66 ± 3.36 |
| T. atroviridae grown on wool medium | 1.00 ± 0.03 | 23.5 ± 0.06 | 2.67 ± 0.02 | 7.33 ± 0.05 | 27.66 ± 1.34 |
| T. asperellum on medium without keratin | 1.32 ± 0.01 | 17.66 ± 0.06 | 2.44 ± 0.05 | 6.33 ± 0.02 | 25.60 ± 2.19 |
| T. asperellum grown on feathers medium | 2.08 ± 0.05 | 29.16 ± 0.19 | 2.96 ± 0.07 | 7.33 ± 0.07 | 35.40 ± 1.14 |
| T. asperellum grown on wool medium | 2.12 ± 0.08 | 24.16 ± 0.17 | 2.92 ± 0.08 | 5.66 ± 0.13 | 24.40 ± 1.14 |
| Control (only water) | 0.53 ± 0.02 | 8.16 ± 0.18 | 2.27 ± 0.13 | 4.66 ± 0.06 | 24.00 ± 1.58 |
© 2019 by the authors. Licensee MDPI, Basel, Switzerland. This article is an open access article distributed under the terms and conditions of the Creative Commons Attribution (CC BY) license (http://creativecommons.org/licenses/by/4.0/).
Share and Cite
Calin, M.; Raut, I.; Arsene, M.L.; Capra, L.; Gurban, A.M.; Doni, M.; Jecu, L. Applications of Fungal Strains with Keratin-Degrading and Plant Growth Promoting Characteristics. Agronomy 2019, 9, 543. https://doi.org/10.3390/agronomy9090543
Calin M, Raut I, Arsene ML, Capra L, Gurban AM, Doni M, Jecu L. Applications of Fungal Strains with Keratin-Degrading and Plant Growth Promoting Characteristics. Agronomy. 2019; 9(9):543. https://doi.org/10.3390/agronomy9090543
Chicago/Turabian StyleCalin, Mariana, Iuliana Raut, Melania Liliana Arsene, Luiza Capra, Ana Maria Gurban, Mihaela Doni, and Luiza Jecu. 2019. "Applications of Fungal Strains with Keratin-Degrading and Plant Growth Promoting Characteristics" Agronomy 9, no. 9: 543. https://doi.org/10.3390/agronomy9090543
APA StyleCalin, M., Raut, I., Arsene, M. L., Capra, L., Gurban, A. M., Doni, M., & Jecu, L. (2019). Applications of Fungal Strains with Keratin-Degrading and Plant Growth Promoting Characteristics. Agronomy, 9(9), 543. https://doi.org/10.3390/agronomy9090543

